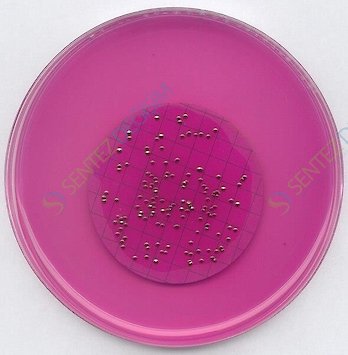
MERCK 111277.0500 M-Endo Agar Les For Microbiology

MERCK 111277.0500 M-Endo Agar Les For Microbiology
| Description |
|---|
| Catalogue Number | 111277 |
| Product Information |
|---|
| HS Code | 3821 00 00 |
| Quality Level | MQ200 |
| Physicochemical Information |
|---|
| pH value | 7.0 - 7.4 (H₂O, 25 °C) (ready-to-use solution),(after autoclaving) |
| Solubility | 51 g/l |
| Safety Information according to GHS |
|---|
| Hazard Statement(s) | H350: May cause cancer. |
| Precautionary Statement(s) | P201: Obtain special instructions before use.P202: Do not handle until all safety precautions have been read and understood.P280: Wear protective gloves/ protective clothing/ eye protection/ face protection/ hearing protection.P308 + P313: IF exposed or concerned: Get medical advice/ attention.P405: Store locked up.P501: Dispose of contents/ container to an approved waste disposal plant. |
| Storage class | 6.1C Combustible, acute toxic Cat.3 / toxic compounds or compounds which causing chronic effects |
| WGK | WGK 3 highly hazardous to water |
| Disposal | 9Carcinogenic compounds and flammable compounds labelled "Highly toxic" or "Toxic": container F. Alkyl sulfates are carcinogenic; Take particular care to avoid inhalation and skin contact. To neutralize alkyl sulfates, add dropwise (from a dropping funnel) to concentrated ice-cool Ammonia solution (Cat.No. 105426) with vigorous stirring. Before placing in container D, check the pH with pH Universal indicator strips (Cat.No. 109535). |
| Safety Information |
|---|
| Categories of danger | carcinogenic |
| Storage and Shipping Information |
|---|
| Storage | Store at +15°C to +25°C. |
| Specifications |
|---|
| Appearance (clearness) | clear to turbid |
| Appearance (color) | red |
| pH-value (25 °C) | 7.0 - 7.4 |
| Growth (Escherichia coli ATCC 25922 (WDCM 00013)) | good to very good |
| Growth (Enterobacter aerogenes ATCC 13048) | good to very good |
| Growth (Proteus mirabilis ATCC 14273) | good to very good |
| Growth (Staphylococcus aureus ATCC 25923 (WDCM 00034)) | none |
| Growth (Enterococcus faecalis ATCC 19433 (WDCM 00009)) | none to poor |
| Colony color (Escherichia coli ATCC 25922 (WDCM 00013)) | red |
| Colony color (Enterobacter aerogenes ATCC 13048) | red |
| Colony color (Proteus mirabilis ATCC 14273) | reddish/red |
| Metallic luster (Escherichia coli ATCC 25922 (WDCM 00013)) | + |
| Metallic luster (Enterobacter aerogenes ATCC 13048) | + |
| Metallic luster (Proteus mirabilis ATCC 14273) | - |
| Incubation: 24 hrs.; 35 °C; aerobic. |